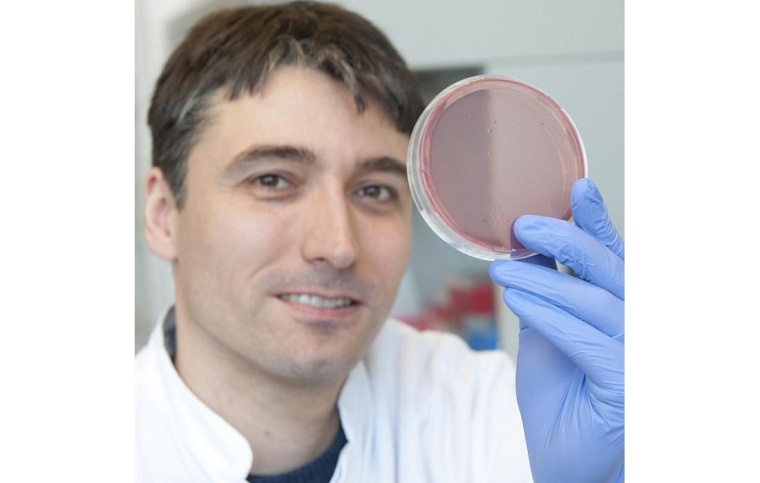
Prof. Christoph Reinhardt vom Centrum für Thrombose und Hämostase (CTH) der...

Einfluss des Darmmikrobioms auf Blutgefäße und Thrombosen
DZHK-Forscher beleuchten in Nature Reviews Cardiology vielfältige Mechanismen im Zusammenspiel von Darmmikrobiom und Thrombosen. Daraus könnten sich neue Ansätze für die Prävention und Behandlung von Thrombosen und damit verbundenen Herz-Kreislauf-Erkrankungen ergeben.
Eine neue wissenschaftliche Übersichtsarbeit in Nature Reviews Cardiology zeigt, dass das Darmmikrobiom auf mehrere Weisen die Entstehung von Thrombosen beeinflusst. Neben der Produktion von Trimethylamin-N-oxid (TMAO) tragen verschiedene bakterielle Stoffwechselprodukte und Entzündungsprozesse zur Thrombusbildung bei. Ein Beispiel ist die bakterielle Umwandlung von Cholin und Carnitin aus Nahrungsmitteln, wie rotem Fleisch, in TMAO, das bekanntermaßen die Thrombozytenaktivierung fördert.
Darüber hinaus zeigen Studien, dass die Darmmikrobiota die Integrität der Darmbarriere beeinflusst (Commensal bacteria weaken the intestinal barrier by suppressing epithelial neuropilin-1 and Hedgehog signaling | Nature Metabolism https://doi.org/10.1038/s42255-023-00828-5). Wenn diese Barriere gestört wird, können endotoxische Substanzen in den Blutkreislauf gelangen und Entzündungsreaktionen auslösen, die zur Thrombosebildung beitragen. Dies führt zu einem erhöhten systemischen Entzündungsniveau, was auch die Gerinnungsneigung des Blutes verstärkt.
Mikrobielle Metabolite und neue therapeutische Ansätze
Zudem spielen kurzkettige Fettsäuren (SCFAs), die von bestimmten Darmbakterien produziert werden, eine Rolle bei der Regulierung von Entzündungen und der Stabilisierung des Endothels, was wiederum die Gerinnungsprozesse modulieren kann. Ein weiteres Beispiel ist die bakterielle Beeinflussung von Gallensäuren, die den Leberstoffwechsel und die Blutfettwerte verändert. Ungleichgewichte in diesen Mechanismen könnten das Risiko für kardiovaskuläre Komplikationen wie Thrombosen erhöhen.
„Unsere Ergebnisse verdeutlichen, dass das Darmmikrobiom weitreichenden Einfluss auf die das Blutgefäßsystem und die Thrombose hat. Durch das Verständnis der mikrobiellen Mechanismen, die Thrombosen begünstigen, eröffnen sich vielversprechende Möglichkeiten für präventive Therapien, die auf die mikrobielle Diversität und die Beeinflussung mikrobieller Metabolite abzielen,“ erklärt Christoph Reinhardt, Letztautor der Studie vom Centrum für Thrombose und Hämostase (CTH) der Universitätsmedizin Mainz.
Diese Forschungsergebnisse eröffnen neue Perspektiven für therapeutische Maßnahmen, darunter gezielte Probiotika, präbiotische Ernährung oder Medikamente, die den Einfluss spezifischer Bakterien und deren Stoffwechselprodukte auf das Gerinnungssystem regulieren könnten. Diese neuen Ansätze könnten helfen, die Prävention und Behandlung von Thrombosen und damit verbundenen Herz-Kreislauf-Erkrankungen grundlegend zu verbessern.
Originalpublikation: The gut microbiota in thrombosis. My Phung Khuu, Nadja Paeslack, Olga Dremova, Corinne Benakis, Klytaimnistra Kiouptsi & Christoph Reinhardt, Nature Reviews Cardiology (2024) https://doi.org/10.1038/s41569-024-01070-6













